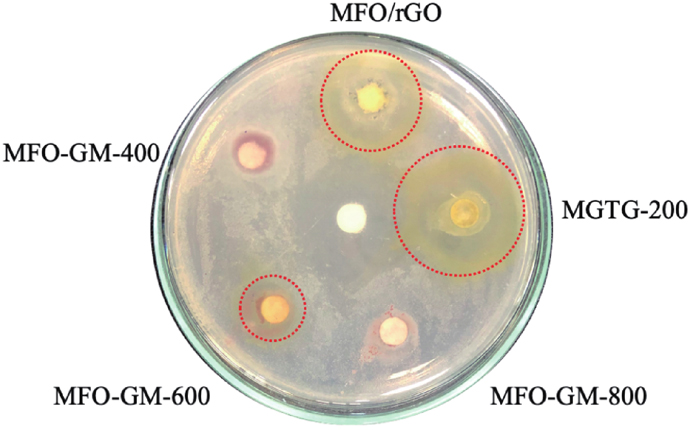
(Color online) Inhibition zone diameter of surveyed materials against S. aureus.

Green synthesis of three-dimensional magnesium ferrite/titanium dioxide/reduced graphene from Garcinia mangostana extract for crystal violet photodegradation and antibacterial activity
1 Introduction
Following the increasing demand of the pharmaceutical and textile industries, complex dyes and pigments have become more widespread, which has also had negative effects on the environment. Especially, in the process of dyeing fibers or fabrics, 10%−50% of untreated dyes are lost and discharged into the surroundings annually[1]. In addition, industrial wastewater contains large amounts of heavy metals, antibiotics, toxic organic substances, surfactants, and so on, which seriously affect the quality of the water sources (surface and groundwater), as well as the environment. In detail, due to the long-term accumulation of untreated industrial waste, the transmission of light is gradually reduced and this disrupts the biological activity of aquatic ecosystems, leading to the strong growth of molds and pathogenic bacteria in the water. Notably, if introduced into the human body through water, the dye molecules might gradually accumulate in the body, causing the inactivation of physiological functions of tissues and cells in the body, and lowering immunity translation of the human health system[2]. Among them, crystal violet (CV) is a common dye that is widely used in biological dyeing, dermatology, veterinary medicine, and dye processing. CV is a common industrial synthetic cationic dye and a member of the triphenylmethane family[3, 4]. Prolonged contact with CV dye leads to respiratory irritation, vomiting, diarrhea, headache, and dizziness. Prolonged exposure can also damage membranes mucus owing to the strong interaction between CV dye molecules and negatively charged cell membrane surfaces[3]. Therefore, there is an urgent requirement to find a method to handle exposure to CV dyes, in particular, and contaminated water remediation, in general.
Dye molecules composed of complex conjugated aromatic rings in wastewater are inert to light, heat, or oxidizing agents, and therefore decolorization is a puzzling problem[5]. Three kinds of pathways—chemical, physical, and biological—of treating contaminated dyed water have all been shown to be efficient. Various removal approaches have been used in the last few years, such as liquid film separation, biological treatment, oxidation, electrolysis, adsorption, chemical catalytic decomposition, ultrafiltration, desalination, and reverse osmosis[6−9]. Nevertheless, the electrochemical and membrane technologies require expensive equipment and conditioning to change the substances' system, whereas the chemical oxidation approach could be used or toxic chemicals (known as hazardous agents or secondary problems) could be released to the environment[10]. The remarkable characteristics of adsorbents (e.g. wide surface area, high sensitivity, higher accuracy, and low cost) have led to the growing use of the adsorption technique for pollutant removal. However, in addition to these benefits, this approach has serious concerns related to the treatment of the adsorption process and the reusability of the material, which limits the scope of their applications. Although this technique is believed to be constructive in removing organic and inorganic contaminants, it is tedious, expensive, requires high processing costs, and is often ineffective in removing fastidious compounds[11]. Therefore, these processes might occasionally remove harmful pollutants but they can also result in the production of undesired substances and health concerns. Photocatalytic decomposition is a method that is comparable and much more efficient than the other methods. This remedial technique, which has gained worldwide attention as the most functional, simple, practical, and non-toxic method, appears to be a promising strategy in the field of pollutant removal. When light approaches and excites the electron on the surface of the catalyst, they rapidly decolorize the textile dyes, using sunlight as an energy source and oxygen from the atmosphere as an oxidant. As a result, the toxic compounds are broken down into non-toxic chemical compounds or eventually become CO2 and H2O. Furthermore, the usage of renewable solar energy for lighting is another huge advantage, making this approach even more environmentally friendly[12].
The fabrication of photocatalysts with semiconductor properties is a promising pathway, specifically titanium dioxide (TiO2). Thanks to the initial findings of Matsunaga et al. on the photocatalytic properties of titanium dioxide/platinum (TiO2/Pt) materials under light excitation, the research on water disinfection, energy production, organic matter conversion, and pollutant decomposition of TiO2 materials has been increasingly consolidated and expanded[13]. Moreover, with outstanding properties such as non-toxicity, affordable cost, chemical stability, and photochemical stability as compared to other semiconductor materials, the focus on environmental treatment in various applications is enabled thanks to the exhibited properties of TiO2[12]. However, whether it exists alone or separately, TiO2 exhibits many notable drawbacks, comprising a wide bandgap energy (~3.2 eV) and kinetically fast recombination of electron-hole pairs, along with poor affinity to organic dye molecules. In addition, due to its wide bandgap energy, TiO2 only really exhibits strong photocatalytic activity in the ultraviolet (UV) irradiation region, leading to the limitations of TiO2 in a lot of fields[12, 14]. In contrast, magnesium ferrite (MgFe2O4 (MFO)) is a known spinel ferrite material with unusual properties, such as magnetocrystalline anisotropy, moderate saturation magnetization, and resistance to optical corrosion in aqueous solution, and is able to absorb light in the visible region due to a low bandgap energy (~2.0 eV) and declining recombination rate of the electron−hole pairs[15]. Thus, doping TiO2 with MFO enhances the photocatalytic activity of the binary composite and diminishes the drawback of each material when used alone. Therefore, the green synthesis of MFO using biochemical substances has emerged and has been used to reduce the number of hazardous chemicals discharged into the surroundings. Contemporarily, various types of plant extracts are being interested due to the facile, affordable, and eco-friendly synthesis process. In particular, the extract of Garcinia mangostana (G. mangostana) consists of a lot of secondary metabolites, such as tannin, xanthone, anthocyanin, total phenol, and so on[16]. Being basically weak, it can act as a mild reducing agent and stabilizer to prevent agglomeration during and after the formation of MFO nano- and microparticles[17, 18]. Moreover, the plant itself is abundant and widespread in multiple Asian regions. However, the binary composites still have a high recombination rate and are easy to be agglomerated[12, 19]. Herein, to tackle this situation, researchers have combined binary composites with carbon-based materials to facilitate electron movement. Among them, significantly, reduced graphene oxide (rGO) is considered to be a promising and outstanding material due to the physicochemical properties of graphene and graphene oxide (GO), which also can be easily synthesized from GO[20, 21]. The rGO material is synthesized from the self-assembly process of ordinary graphene sheets via van der Waals, π−π, and ionic bonds, or from the interactions between graphene sheets and binding agents (e.g. poly (vinyl alcohol), chitosan, stearic acid, etc.)[22, 23]. The porous 3D network facilitates the diffusion of pollutants, adsorption of toxic metals, and catalytic surface area, as well as providing efficient charge separation, all of which contribute to the applicable widespread of graphene-based materials[24]. The combination of TiO2 and MFO decorated on the rGO framework is expected to be a potential approach due to reduced agglomeration of materials and enhanced charge−carrier separation, as well as the extended lifetime of the photogenerated electron−hole pair. Therefore, based on the three-dimensional structure, large surface area, and abundance of active sites of rGO materials, the adsorption capacity of dye molecules toxicity in the aquatic aqueous is also modified[25].
In this work, three-dimensional porous magnesium ferrite−titanium dioxide/reduced graphene oxide (MgFe2O4-GM/TiO2/rGO (MGTG)) was fabricated via green and hydrothermal-supported co-precipitation methods using the extract of G. mangostana as reducing agent. The produced materials were thoroughly characterized via modern analytic methods, including field emission scanning electron microscopy (FE-SEM), energy-dispersive X-ray spectroscopy (EDX), Fourier-transform infrared spectroscopy (FTIR), X-ray diffraction (XRD), ultraviolet–visible (UV–Vis) spectroscopy, Raman spectra, and thermogravimetric analysis (TGA). The electrochemical capability of the surveyed samples was also evaluated through, zeta potential (ZP) measurements, electrochemical impedance spectroscopy (EIS), and cyclic voltammetry (CVm) curve. The photocatalytic traits of the selected materials were then investigated regarding the degradation of CV under illumination. Additionally, the photodegradation process was also investigated with the pseudo-first-order kinetic model. Their antibacterial activities were studied against the Gram-positive bacterial strain Staphylococcus aureus (S. aureus) by measuring the inhibition zone diameter.
2 Materials and methods
2.1 Materials and chemicals
Graphite (particle size < 20 µm), titanium (Ⅳ) isopropoxide (TIP), and CV (C25H30ClN3) were purchased from Sigma-Aldrich Co. Ltd., USA. Iron (Ⅲ) nitrate nonahydrate (Fe(NO3)3∙9H2O), magnesium nitrate hexahydrate (Mg(NO3)2∙6H2O), ammonium hydroxide (NH4OH), sulfuric acid (H2SO4, 98%), phosphoric acid (H3PO4, 85%), potassium permanganate (KMnO4), hydrogen peroxide (H2O2, 30%), polyvinylpyrrolidone (PVP), acetic acid (CH3COOH), ethanol (C2H5OH), ethylenediamine tetraacetic acid disodium salt (EDTA), p-benzoquinone (BQ), and isopropanol (IPA) were purchased from Xilong Scientific Co. Ltd., China. All chemicals were utilized without further purification and double distilled water was used for all experiments.
2.2 Extraction of G. mangostana pericarp
G. mangostana pericarps were obtained from the Hoc Mon market, Viet Nam. The collected pericarps were carefully washed with distilled water before being dried at 60 °C and ground to collect a fine powder. After that, 10 g of powder was added to a 200 mL mixture of ethanol and distilled water (1 : 1) and heated to 90 °C for 1 h. The collected G. mangostana extract was then vacuum filtered to remove impurities and stored at 20 °C before utilization.
2.3 Synthesis of MgFe2O4 using extraction of G. mangostana pericarp reducing agent
MFO synthesized using G. mangostana pericarp extract (MFO-GM) nanocomposite was synthesized using the co-precipitation method. At first, 1.28 g Mg(NO3)2∙6H2O and 4.04 g Fe(NO3)3∙9H2O were dissolved in 100 mL of distilled water. The solution was then slowly added with 5 g PVP and 10 mL of NH4OH, respectively, under stirring at 80 °C for 2 h. After that, the product was centrifuged and rinsed with distilled water to collect the solid. Finally, the sample was calcinated at 600 °C for 2 h to collect the MFO-GM powder. The influence of calcination temperatures on the formation of MFO-GM was also examined at 400, 600, and 800 °C, corresponding to the MFO-GM-400, MFO-GM-600, and MFO-GM-800 samples, respectively.
2.4 Synthesis of MGTG
The MGTG material was synthesized via the hydrothermal method. Initially, GO was prepared using the modified Hummers’ method[26]. A determined amount of MFO-GM was added with GO to form a suspension mixture and sonicated for 30 min. Then, a mixture of TIP : acetic acid : ethanol (volume ratio of 1 : 1 : 15) was added to the prepared suspension under sonication for 15 min. The obtained mixture was subsequently put in a Teflon autoclave and underwent the hydrothermal process at 180 °C for 2 h to form a hydrogel. Finally, the hydrogel was freeze-dried at −80 °C for 48 h to acquire MFO/TiO2/rGO composite (MGTG). MFO-GM contents were also investigated from 100, 150, 200, 250, and 300 mg, corresponding to the MGTG-100, MGTG-150, MGTG-200, MGTG-250, and MGTG-300 samples, respectively. The synthesis procedure of MGTG materials is depicted in
2.5 Characterization of materials
FE-SEM micrographs (Hitachi S4800, Japan) were obtained to investigate the morphology and structure of fabricated materials, while EDX spectra (Jeol JMS 6490, Japan) were also conducted to study their elemental compositions. To investigate the functional groups arising from the material surfaces, FTIR spectra (Bruker TENSOR-27, Germany) were recorded by the KBr-pellet method in the wavelength of 600 to 4000 cm−1 with an accuracy of 0.1% T and resolution of 0.2 cm−1. XRD diffractograms (Bruker XRD D8, Germany) were also acquired via CuKα irradiation (λ = 0.154 nm) at 2θ = 0°−80° and a scanning rate of 2° min−1. Meanwhile, TGA analyses (Thermo Plus TG-8120) were evaluated to determine the thermal behaviors of surveyed materials, in which 50 mg of each was heated over 20 to 800 °C with a temperature and airflow rates of 10 °C/min and 50 mL/min, respectively. In addition, Raman spectra (LabRam micro-Raman) were collected at the excitation wavelength of 632 nm using a He−Ne laser, whilst Zetasizer Nano (Malvern ZS90) was also utilized for zeta potential measurement.
Regarding electrochemical investigations, CVm and EIS curves of synthesized materials were performed similarly to previous research[27]. Specifically, 90% of MFO-GM powder and 10% of carbon black were mixed and dispersed in 10 mL ethanol to prepare a glass carbon electrode, serving as an electrode in a three-electrode system for electrochemical measurement.
2.6 Photocatalytic degradation of CV
To investigate the photocatalytic performance of MGTG, the material was subjected to the photodegradation of CV, a common industrial organic dye, under light irradiation. In particular, 100 mL of CV solution (30 mg/L) was added with 20 mg of MGTG and continuously stirred in the dark for 60 min to reach adsorption−desorption equilibrium, before being illuminated with two 11-W UV lamps for 80 min. After each 20-min of irradiation, 4 mL of the mixture was withdrawn, filtered with a 0.22 μm nylon filter, and quantified the residual CV concentration using UV−Vis spectroscopy at the wavelength of 587 nm. Subsequently, the photodegradation efficiency (H, %) was calculated according to Eq. (1):
where Ao and A are the initial and final absorbances of the sample, respectively.
The photocatalytic kinetics were also examined based on the pseudo-first-order model in Eq. (2):
where Co and C (mg/L) are the initial and residual CV concentrations, respectively; k (min−1) is the reaction rate constant, and t (min) is the reaction time.
In addition, the reusability of MGTG was further evaluated for 10 reusing runs. After each cycle, the material was recovered via centrifugation, washed with ethanol and distilled water, and dried at 60 °C, before being utilized for the succeeding run.
2.7 Antibacterial activity
An agar disc diffusion assay was used to evaluate the antibacterial activity of two samples MFO-GM and MGTG. The antibacterial properties of the samples were analyzed through the measurement of the inhibition diameter zone. Accordingly, all equipment was sterilized by autoclave at 121 °C for 20 min before conducting the experiments. Growth inhibition assays were carried out to assess the bacteriostatic effect against S. aureus which is known to be a typical strain of Gram-positive. In addition, indicator organisms were multiplied in agar. The agar containing the indicator microorganisms was prepared and poured into a petri dish. After solidification, a well was generated by perforating a 5 mm well, and antibacterial activity was determined. The diameters of inhibition zones were measured in mm including similar welling diameters when excluding size[28].
3 Results and discussion
3.1 Characterization of materials
The morphology of the MFO-GM samples calcinated at different temperatures was examined via FE-SEM images in

Fig. 2. (Color online) FE-SEM images of (a) MFO-GM-400, (b) MFO-GM-600, (c) MFO-GM-800, and (d) MGTG-200.
Furthermore, as can be witnessed in
To affirm the crystallinity of the MFO-GM samples and MGTG-200, their XRD patterns were studied, as described in

Fig. 4. (Color online) (a) XRD patterns of MFO-GM and MGTG-200 samples and (b) Raman spectrum of MGTG-200.
The thermal behavior of the MGTG-200 was scrutinized via the TGA curve, as indicated in
The zeta potentials of the MGTG-200 and MFO-GM-600 are demonstrated in
The electrochemical behaviors of the MFO-GM-600 and MGTG-200 were also evaluated via the EIS and CV analysis, as indicated in

Fig. 7. (Color online) (a) EIS Nyquist and (b) CV curves of MGTG-200 at different scan rates.
In addition, the electrochemical property of the MGTG-200 was also investigated via the CV curve within the potential window from 0 to 1.0 V with different scan rates. In particular, the CV curve of the MGTG-200 at the scan rate of 0.05−0.1 V∙s−1 is indicated in
3.2 Photocatalytic degradation of CV
The photocatalytic potential of synthesized materials was subsequently examined as the photodegradation of CV under light irradiation. According to the data in
The photocatalytic activity of the selected MGTG-200 sample was also investigated via the catalyst dose, CV concentration, and pH level. Regarding the catalyst dose, as can be witnessed in

Fig. 9. (Color online) Effects of (a) catalyst dose, (b) pH level, and (c) CV concentration on the photocatalytic efficiency of MGTG-200.
The photocatalytic rate of the material was also promoted as the solution turns more basic (
The initial dye concentration itself is also among the crucial factors influencing the photocatalytic efficiency of MGTG-200. According to
Moreover, the CV photodegradation activity of the MGTG-200 catalyst was also assessed via the kinetic regression model of the pseudo-first-order reaction. The experiments were performed at the selected optimal conditions, in which all data points locate surrounding the regression line, indicating great accuracy. As can be seen in

Fig. 10. (Color online) (a) Kinetic studies for the CV photodegradation and (b) recovery and reusability efficiency after 10 cycles of MGTG-200.
CV photodegradation efficiency of several materials.
| No. | Materials | Catalyst dose (mg) | CV concentration (mg/L) | Reaction time (min) | Photodegradation rate (%) | References |
|---|---|---|---|---|---|---|
| 1 | MGTG-200 | 20 | 20 | 120 | 99.23 | This study |
| 2 | CaCO3/g-C3N4 | 80 | 20 | 120 | 76 | [ |
| 3 | SA-g-poly/ZnO/GO | 100 | 30 | 300 | 94 | [ |
| 4 | AgBiS2/gC3N4 | 30 | 20 | 60 | 71.81 | [ |
| 5 | KBiO3/g-C3N4 | 16 | 20 | 40 | 95 | [ |
It should be noted that the CV photodegradation of the MGTG-200 under UV radiation solely relies on the generated ROS. Thus, the effects of different radical scavengers such as EDTA, BQ, and IPA were also investigated to evaluate the role of different free radicals such as

Fig. 11. (Color online) (a) Effects of radical scavengers on CV photocatalytic degradation under UV light and (b) photocatalytic scheme of the MGTG-200 material.
The photocatalytic pathway of the MGTG material can be suggested similarly to previous research, which involves the transfer and recombination process of electron−hole (e−−h+) pairs[58]. As the material surface was irradiated, photo-induced e−−h+ pairs were generated, in which the formed electrons were subsequently transferred from the valence band of the pristine MgFe2O4 and TiO2 to the conduction band, while the positive holes stayed structurally in the valence band of these nanoparticles. After that, the existing electrons in the conduction band once again traveled to the surface of rGO and participated in multiple reactions to generate ROS, such as
3.3 Antibacterial activity
The antibacterial capability of the surveyed samples was recorded by measuring the inhibition zone diameter, as indicated in
Fig. 12. (Color online) Inhibition zone diameter of surveyed materials against S. aureus.
The inhibition zone diameters of reported materials are listed in
Inhibition zone diameter towards S. aureus of several materials.
| No. | Materials | Material concentration (mg/L) | Inhibition zone diameter (mm) | References |
|---|---|---|---|---|
| 1 | MGTG-200 | 10 | 20 | This study |
| 2 | Se-NPs | 62.5 | 12.2 | [ |
| 3 | Ag2S-ZnO/GO | 20 | 12 | [ |
| 4 | CeO2/g-C3N4 | 70 | 18.9 | [ |
| 5 | ZnO/NiO/g-C3N4 | 400 | 17 | [ |
As shown in
4 Conclusions
In this study, the three-dimensional porous magnesium ferrite−titanium dioxide/reduced graphene oxide (MGTG) was successfully synthesized via green and hydrothermal-supported co-precipitation methods using the extract of G. mangostana as a reducing agent. The electrostatic interaction between MgFe2O4 and rGO plays a crucial role in the dispersion and embedment of the MgFe2O4 on the corrugated structure of the rGO. Furthermore, the synergic influences of the rGO and the nanoparticles also contribute to the enhancement of the CV photodegradation activity. The results also indicated that the MGTG-200 containing 200 mg MFO-GM-600 showed the highest CV removal efficiency of 99.23% under the following conditions: catalyst dosage of 20 mg, CV concentration of 20 mg/L, and pH 10. Compared to previous studies, the material provides competitive performance with high stability and recoverability with the CV removal efficiency of the material still reaching 92% after 10 cycles. Additionally, the photodegradation process of the material also obeys the pseudo-first-order kinetic model with the correlation coefficient R2 = 0.9946. In addition, based on the evaluation of the effect of radical scavenging agents, the results also indicate that
Article Outline
Tong Hoang Lin, Che Quang Cong, Nguyen Thanh Hoai Nam, Hoang An, Nguyen Duy Hai, Ton That Buu, Thoi Le Nhat Binh, Hoang Le Minh, Lam Thanh Ngan, Hoang Thuy Kim Ngan, Du Chi Vi, Ta Dang Khoa, Nguyen Huu Hieu. Green synthesis of three-dimensional magnesium ferrite/titanium dioxide/reduced graphene from Garcinia mangostana extract for crystal violet photodegradation and antibacterial activity[J]. Journal of Semiconductors, 2023, 44(12): 122702.









